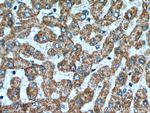
OPA3 Antibody in Immunohistochemistry (Paraffin) (IHC (P))

Search
Proteintech
OPA3 Polyclonal Antibody
{{$productOrderCtrl.translations['antibody.pdp.commerceCard.promotion.promotions']}}
{{$productOrderCtrl.translations['antibody.pdp.commerceCard.promotion.viewpromo']}}
{{$productOrderCtrl.translations['antibody.pdp.commerceCard.promotion.promocode']}}: {{promo.promoCode}} {{promo.promoTitle}} {{promo.promoDescription}}. {{$productOrderCtrl.translations['antibody.pdp.commerceCard.promotion.learnmore']}}
产品信息
15638-1-AP
种属反应
已发表种属
宿主/亚型
分类
类型
抗原
偶联物
形式
浓度
规格
纯化类型
保存液
内含物
保存条件
运输条件
产品详细信息
Immunogen sequence: ANRIKEAAR RSEFFKTYIC LPPAQLYHWV EMRTKMRIMG FRGTVIKPLN EEAAAELGAE LLGEATIFIV GGGCLVLEYW RHQAQQRHKE EEQRAAWNAL RDEVGHLALA LEALQAQVQA APPQGALEEL RTELQEVRAQ LCNPGRSASH AVPASKK (24-179 aa encoded by BC005059)
靶标信息
The mouse ortholog of this protein co-purifies with the mitochondrial inner membrane. Mutations in this gene have been shown to result in 3-methylglutaconic aciduria type III and autosomal dominant optic atrophy and cataract. Multiple transcript variants encoding different isoforms have been found for this gene.
仅用于科研。不用于诊断过程。未经明确授权不得转售。
生物信息学
蛋白别名: 3-methylglutaconic aciduria type III; FLJ22187; FLJ25932; MGC75494; OPA3 outer mitochondrial membrane lipid metabolism regulator; optic atrophy 3 (autosomal recessive, with chorea and spastic paraplegia); Optic atrophy 3 (Iraqi-Jewish 'optic atrophy plus'); Optic atrophy 3 protein; Optic atrophy 3 protein homolog; unnamed protein product
基因别名: D630048P19Rik; Gm1425; Gm472; MGA3; OPA3
UniProt ID: (Human) Q9H6K4, (Mouse) Q505D7
Entrez Gene ID: (Human) 80207, (Mouse) 403187, (Rat) 308409